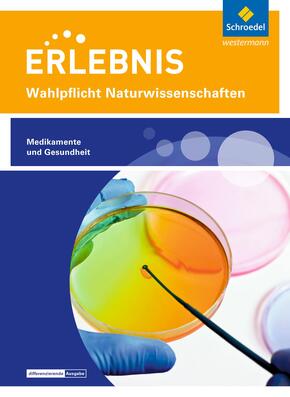

Wahlpflichtfach: Themenheft Medikamente und Gesundheit - Themenheft Medikamente und Gesundheit Wahlpflichtfach
| Verlag | Westermann Bildungsmedien |
| Auflage | Mai 2020 |
| Seiten | 80 |
| Format | 19,0 x 26,0 x 1,0 cm |
| Gewicht | 201 g |
| Reihe | Erlebnis Naturwissenschaften |
| ISBN-10 | 3507700999 |
| ISBN-13 | 9783507700994 |
| Bestell-Nr | 50770099A |
Die Themenhefte für den Wahlpflichtunterricht sind da!
Auf Basis des erfolgreichen ERLEBNIS-Konzeptes treffen die Themenhefte exakt die Philosophie des Wahlpflicht-/Projektunterrichtes.
Erweiterte Inhalte, vertiefende und praxisorientierte Aufgaben, sowie die fächerverbindende Betrachtung von Themenkomplexen lassen Ihren Unterricht zum Erlebnis werden. Die Kompetenzbereiche Erkenntnisgewinnung und Kommunikation stehen bei den Aufgabenstellungen stets im Vordergrund.
Die Aufgaben und Texte stellen einen Bezug zur Berufswelt her und es wird besonderes Augenmerk auf die Auswirkungen des menschlichen Handelns auf die Alltagswelt gelegt.
Mit einer klaren 3-fach-Differenzierung eignen sich die Hefte bestens für den Einsatz im praxisorientierten Wahlpflichtunterricht in heterogenen Lerngruppen.
Hinweis: Zu diesem Themenheft wird kein digitales Unterrichtssystem erscheinen.